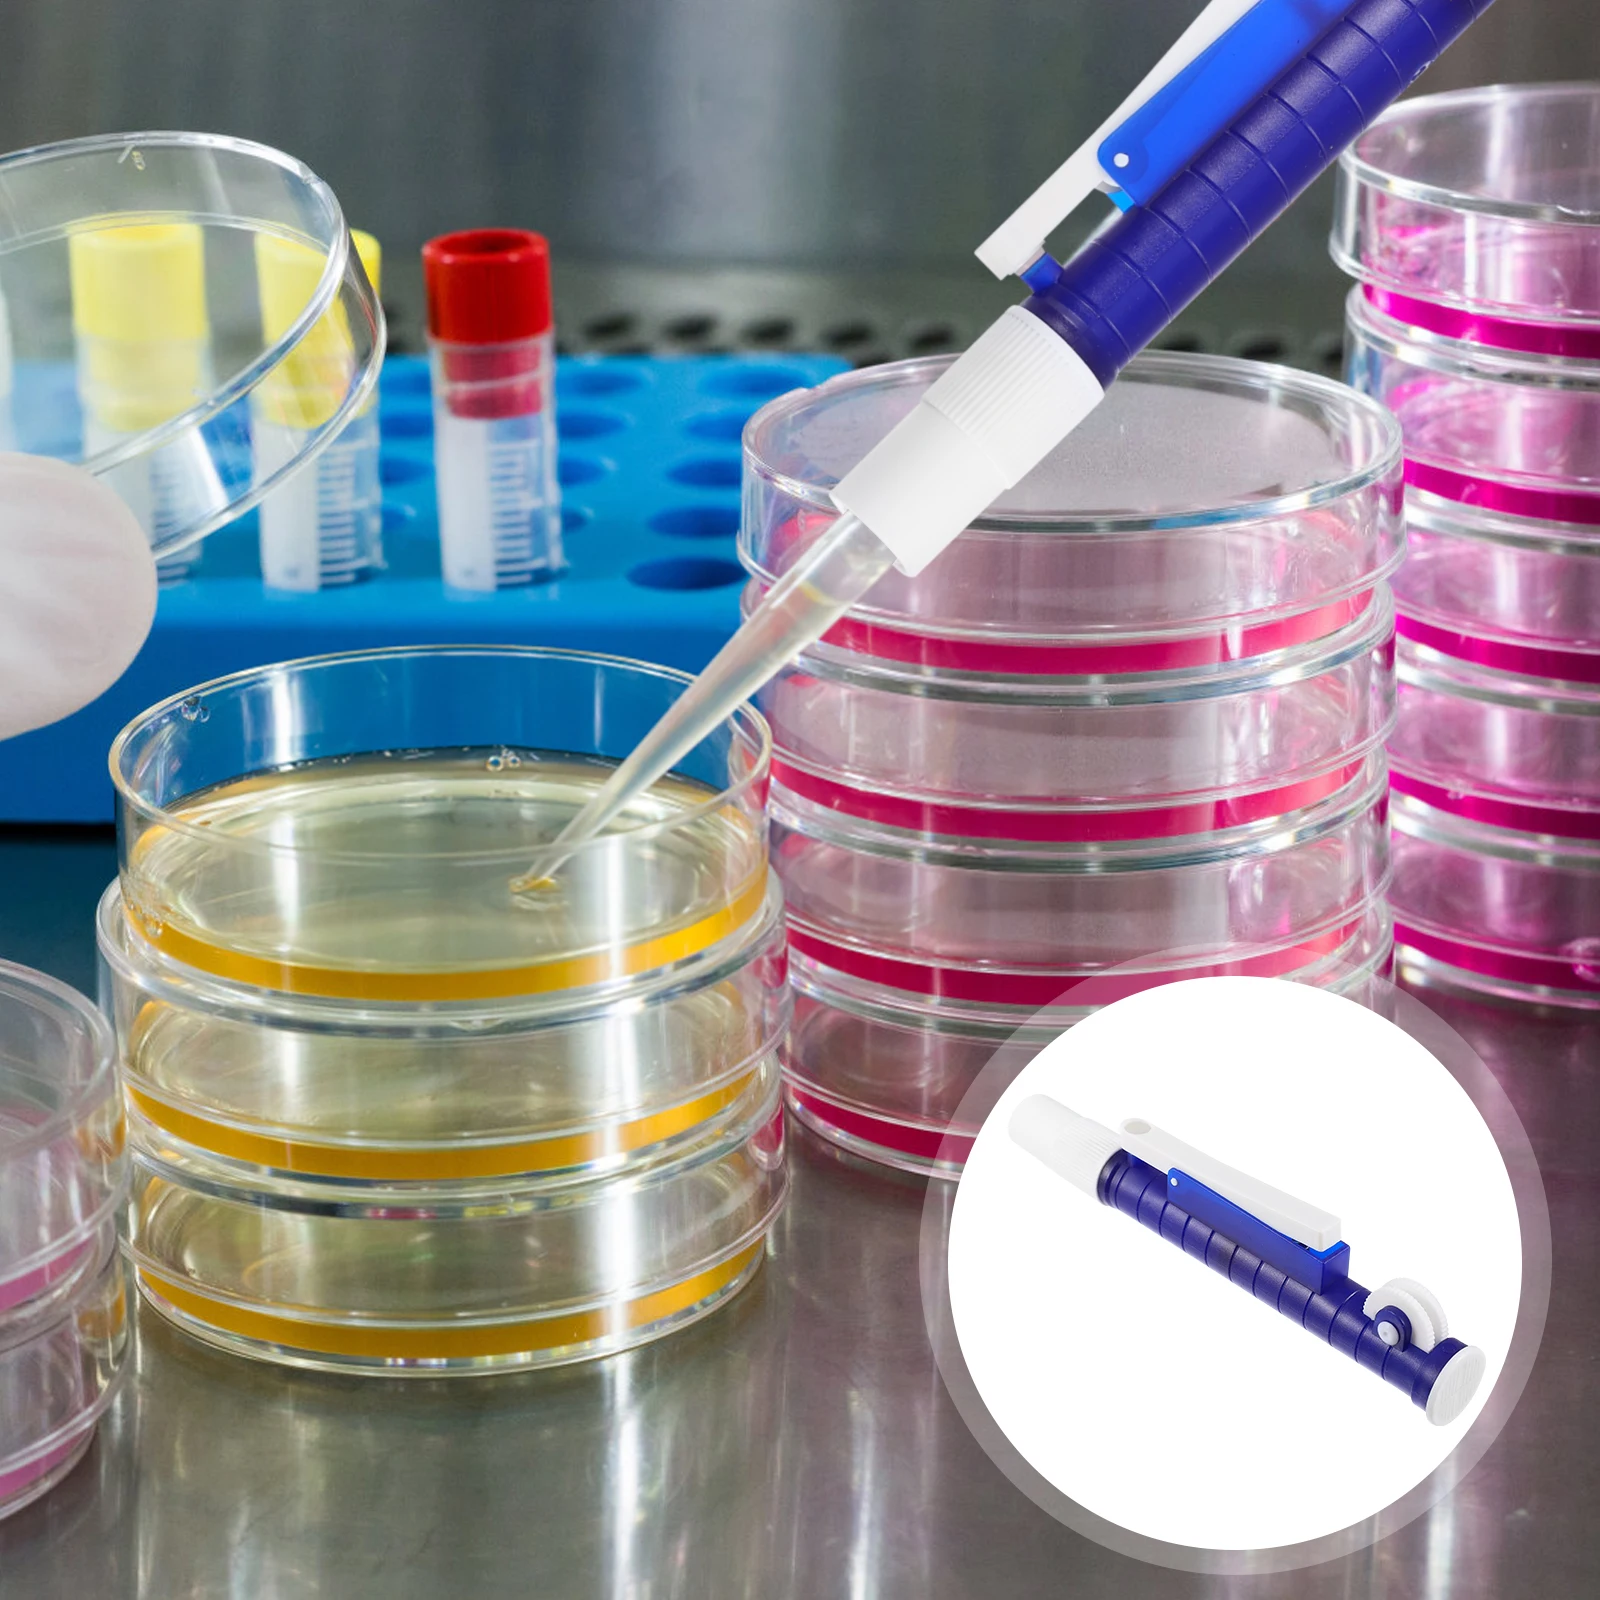
Labs Pipette Pump Plastic Thumb Wheel Design Easy One-Hand Operation Rapid Dispensing Scientific Laboratory Instrument Suction

Wifi Thermostat For HVAC System Heat Pump,Smart Programmable Temperature Controller Work For Alexa, Google Home
Price history chart & currency exchange rate
Customers also viewed

$6.41
Shiny Furret Walk Meme Pillow Case 20x30 50*75 Sofa Bedroom Pattern Pilot Black Fan Art Long Rectangle Pillowcover Home Outdoor
aliexpress.com
$112.99
Комплект Картера 6B4-15100 для подвесного 2-х тактного двигателя Yamaha, 9,9 л.с., 15 л.с., новая модель 15D 9,9d Enduro Series 6B4-15100-00-1S
aliexpress.ru
$5.24
Профессиональные железные бочки для полета ПЭТ, набор из 12 шт., 14 граммов, качественные наборы дротиков со стальным и дротиком
aliexpress.ru
$13.01
Официальный джентльменский костюм для мальчиков, белая футболка с галстуком-бабочкой, жилет, шорты на бретелях, набор для крещения, дня рождения, свадьбы
aliexpress.ru
$5.43
Gabby кукольный домик плюшевая игрушка Mercat мультфильм мягкие животные Русалка Кот Русалка плюшевые куклы
aliexpress.ru
$9.64
Рукоятка багажника БАГАЖНИКА АВТОМОБИЛЯ, ручка переключателя для Ford New Focus 2015-2018
aliexpress.ru
$31.51
Original DC18RD Double Charger Li-ion Rechargeable Battery Charger for Makita 14.4V 18V BL1850 BL1830 BL1860 BL1840 BL1415
aliexpress.com$35.19
Konica Minolta oryginalny developer A202550/A202500, 120000s, Konica Minolta Bizhub 223, 283, 363, 423
wasserman.eu
$17.93
Женское платье с коротким рукавом, Пляжная накидка с принтом из спандекса, летняя одежда для отпуска, парео, бикини, новинка 2023
aliexpress.ru
$14.46
10 шт. алмазная живопись художественные подставки бабочка цветок с держателем мозаика рукоделие деревянные Нескользящие изоляционные кухонные принадлежности подарки
aliexpress.ru
$9.84
SKOWLL напольная дренажная сетка, крышка, фурнитура для кухни и ванной комнаты, детали из нержавеющей стали 304
aliexpress.ru
$19.29
Ремешок из титанового сплава для Samsung Galaxy Gear S3 Frontier / Classic / Galaxy Watch 3 45 мм/Galaxy 46 мм, металлический браслет для наручных часов
aliexpress.ru$260.28
Frankhauer Materac wysokoelastyczny Mojry 18 cm (pokrowiec Margrita, rozmiar 90 x 180*)
wasserman.eu
$136.00
LCD Electric Pruning Shears 600W Brushless Cordless Pruner Lithium Powered Fruit Tree Bonsai Pruning with 2 Battery
aliexpress.com
$34.99
HamGeek Zigbee 3.0 Coordinator Router Zigbee Gateway Wifi Router for HamGeek CC2652P Module Zigbee2mqtt
aliexpress.com
$749.48
Ноутбук Tecno Megabook T1 R7 15 16G+1T DOS Silver (AMD Ryzen 7 5800U 1.9GHz/16384Mb/1Tb/AMD Radeon Graphics/Wi-Fi/Cam/15/DOS), TCN-T1R7D15.1.SL
pleer.ru
$20.19
maternity bottoms shorts summer cotton breathable middle leggings for pregnancy women prenant fashion cat pattern/pure 5-leggings, White
dhgate.com
$56.89
women's sleepwear print leopard 4pcs loose lace women kimono robe gown satin home clothing casual lounge spring intimate lingerie, Black;red
dhgate.com
$825.00
15.6 inch Motorized car roof mounted DVD monitor ceiling flip down overhead player
aliexpress.com
$75.89
Набор инструментов AUTOVIRAZH AV Steel AV-011076 76 предметов, AV Steel AV-011076 76 предметов
imarket.by
$96.77
casual dresses modern ruched v neck lapel black wrap dress long sleeve draped tight waist solid formal mini bodycon club femme, Black;gray
dhgate.com
$8.72
Коллективная шапка Sullen Art 3212, женские береты, Мужская зимняя шапка, Шерстяная Шапка-бини, мужской берет, женские шапки, шапки в стиле хип-хоп, ...
aliexpress.ru
$2.48
Устойчивая К Царапинам Общая Крышка Жесткого ПК С HD Закаленным Стеклянным Стеклоэкранным Защитником Для Часов Huawei GT 3 42 Мм - Прозрачный, Other Huawei Models
tvc-mall.com
$202.50
Full Face Motorcycle helmet X14 fiberglass Helmet ant Riding Motocross Racing Motobike Helmet
aliexpress.com
$5.29
Summer 2020 Leather Deformation Slipper Men's Size 45 Rome Style Sandals Outdoor Beach Casual Flip-Flops Non-slip Waterproof
aliexpress.com
$26.71
BIGTREE Concise Buckle Women's Dress Sandals Super High Heels Pumps Open Toe Red Wedding Sandals Women Thin Heel Patent Leather
aliexpress.com
$125.34
Short Men's Suits Sleeve Sets of Neck Thin Diamond Long-sleeved Stone Sweaters 2020 Hot Drill Design 7ydp, Black
dhgate.com
$32.92
женщины nusring топы с коротким рукавом беременных блуза для кормящих одежда для беременных o-образным вырезом в полоску блузка топы allaite, White
dhgate.com
$1,661.73
new formal men dress shoes leather office party mens shoes black lace up thick platform male social shoe 5cm plus size us 4-11.5
dhgate.com
$25.85
Трость для джентльмена с длинными ушками белого кролика, модная трость для джентльмена, ручка для джентльмена, трость 93 см
aliexpress.ru
$48.02
Повседневные толстые меховые куртки женские с длинным рукавом и v-образным вырезом осень-зима пальто из искусственного меха мода 2025 роскошная куртка уличная верхняя одежда
aliexpress.ru
$11.25
Американские готические старые струйные расписные буквенные принты, двухслойные спортивные повседневные брюки, мужские свободные модные брюки в стиле хип-хоп, рэп, уличные
aliexpress.ru












![Компьютер Jet Gamer [5R2600D8HD1SD48RX58L4W6], Gamer
Компьютер Jet Gamer [5R2600D8HD1SD48RX58L4W6], Gamer](http://imarket.by/upload/iblock/fac/fac1b829bc6e3e815336c0ff0bf5e56c.jpg)